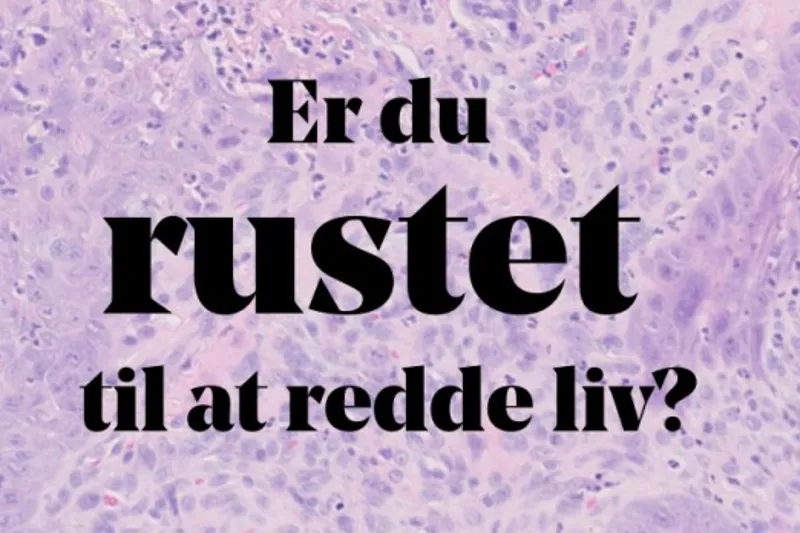

Hver tredje orale cancer opdages i tandlægestolen
Tandlæger har en nøglerolle i at opdage tidlige stadier af oral cancer, da de ser patienterne regelmæssigt. Men det er helt afgørende, at tandlægerne er godt klædt på til opgaven og kender risikogrupperne, lyder det fra eksperter og patientforening.
Hvert tredje tilfælde af oral cancer bliver opdaget i tandlægestolen. Tandlæger kan derfor være med til at redde liv ved at opdage forstadier til cancer eller egentlig cancer i tide og sende patienten videre til yderligere udredning.
– Tandlæger spiller en ekstrem vigtig rolle! Det har utrolig stor betydning for patientens prognose, at cancer bliver opdaget så tidligt som muligt. Så her kan du som tandlæge virkelig være med til at gøre en forskel og redde liv, understreger Lars Nygaard, der er partner hos Evident Tandlægerne og er specialiseret i behandling af hovedhals-kræft-patienter.
Han har arbejdet inden for området i 25 år, og hans oplevelse er, at hovedparten af tandlægerne er gode til at diagnosticere patienterne tidligt i forløbet og henvise dem hurtigt videre i systemet.
– Der er kommet øget fokus på området, og de fleste tandlæger er gode til at spørge kollegaer til råds og få det dobbelttjekket, hvis de ikke selv kan afgøre en given opdagelse, forklarer Lars Nygaard.
Også Jesper Reibel, der er professor ved Odontologisk Institut i København, mener, at landets tandlæger er blevet bedre til at opdage de tidlige faser af oral cancer.
– Tandlægerne ser jo en meget stor del af Danmarks befolkning regelmæssigt og har derfor også en god mulighed for at opdage cancer tidligt. Men det er alfa og omega, at tandlægerne er klar over, hvad de skal se efter, og undersøger mundslimhinderne grundigt visuelt og ved palpation hos alle patienter – inklusive de regionale lymfeknuder.
Svært for tandlæger at blive eksperter
Antallet af danskere, der hvert år bliver ramt af oral cancer, har tidligere været stigende, men har nu stabiliseret sig. De seneste tal fra det fællesnordiske cancerregister, Nordcan, viser, at lidt under 400 danskere hvert år får konstateret cancer i mundhulen (inkl. tunge og læber, men ekskl. tungebasis, bløde gane og uvula).
Det er heldigvis stadig relativt få, der hvert år bliver ramt af sygdommen. Patientnetværket for hals-og mundhulekræft advarer derfor om, at det kan være svært for de praktiserende tandlæger at blive eksperter i at opdage og diagnosticere cancer, fordi de måske kun støder på den en håndfuld gange i deres arbejdsliv.
– Tandlæger ser ikke ret mange af os, og der er altid risiko for, at man ikke fanger det, der skal fanges. Vi hører selvfølgelig om tilfælde, hvor folk bliver henvist for sent, og speciallægen derefter diagnosticerer cancer, siger Niels Jessen, formand for Patientforeningen.
Det er alfa og omega, at tandlægerne er klar over, hvad de skal se efter, og undersøger mundslimhinderne grundigt
JESPER REIBEL, PROFESSOR VED ODONTOLOGISK INSTITUT, KU
Vigtigt at kende risikogrupperne
Dobbelt så mange mænd som kvinder får ifølge Kræftens Bekæmpelse konstateret oral cancer, og sygdommen er mest udbredt hos personer over 35 år. Ifølge Jesper Reibel er det vigtigt, at tandlægerne kender risikogrupperne: rygere, personer med stort alkoholforbrug, socioøkonomisk dårligere stillede borgere, hjemløse osv.
– Tandlæger ville utvivlsomt kunne opdage flere tidlige orale cancere, hvis flere i disse grupper gik regelmæssigt til tandlæge. Meget tyder på, at tandlæger er lige så gode til at få deres patienter til at holde op med at ryge som andre i sundhedssystemet, siger Jesper Reibel.
Og selvom der ikke er videnskabelig evidens for, at et generelt screeningsprogram for befolkningen for oral cancer, som ved visse andre cancertyper, er effektivt, mener Jesper Reibel, at en screening af visse risikogrupper måske kunne være effektivt.
Lars Nygaard er enig i karakteristikken af den typiske hoved-hals-kræft-patient, men understreger, at der i løbet af de seneste 10-15 år er sket en eksplosiv stigning i antallet af hoved-hals-cancer-tilfælde relateret til HPV, så denne gruppe nu udgør minimum 1/3 af det samlede antal.
– Det er en sindssygt vigtig pointe, fordi tandlægen kan være afgørende for at opdage også disse typer cancertilfælde i tide. Risikogruppen her er typisk mænd mellem 40-60 år, der ikke har røget og drukket og fx klager over hævede mandler og lymfeknuder, understreger Lars Nygaard.
Symptomer kan snyde selv den erfarne kliniker
En asymptomatisk 55-årig kvinde er blevet henvist til Kæbekirurgisk Afdeling, Sydvestjysk Sygehus Esbjerg for at få fjernet gingivale hyperplasier pga. dårlig pasform på en 35 år gammel undermundsprotese. En klinisk undersøgelse viser slimhindehyperplasier med fissurering, hvilket tillægges den langvarige irritation. Patienten får fejlagtigt stillet diagnosen irritationshyperplasier.
Patienttilfældet indgår i artiklen ”Tandlægers og specialtandlægers diagnostiske præcision i forbindelse med orale planocellulære karcinomer”.
Patienten er en af fire cancertilfælde, hvor både praktiserende tandlæge og specialtandlæger bliver snydt af symptomerne. Fælles for de fire eksempler er, at de alle havde få typiske kliniske maligne karakteristika kombineret med en lav risikoadfærd.
Der indgår i alt 56 patienter med oral cancer i artiklen, som er blevet henvist fra privat praksis. Af dem er 36 % henvist korrekt på mistanke om malignitet, mens de resterende 64 % blev henvist som rutine uden malignitetsmistanke.
Ifølge artiklens forfattere afspejler de falsk negative henvisninger muligvis en diagnostisk tøven hos tandlægen, som måske heller ikke ønsker at konfrontere patienten med sin mistanke. En tøven og en hensyntagen, der desværre kan have fatale konsekvenser.